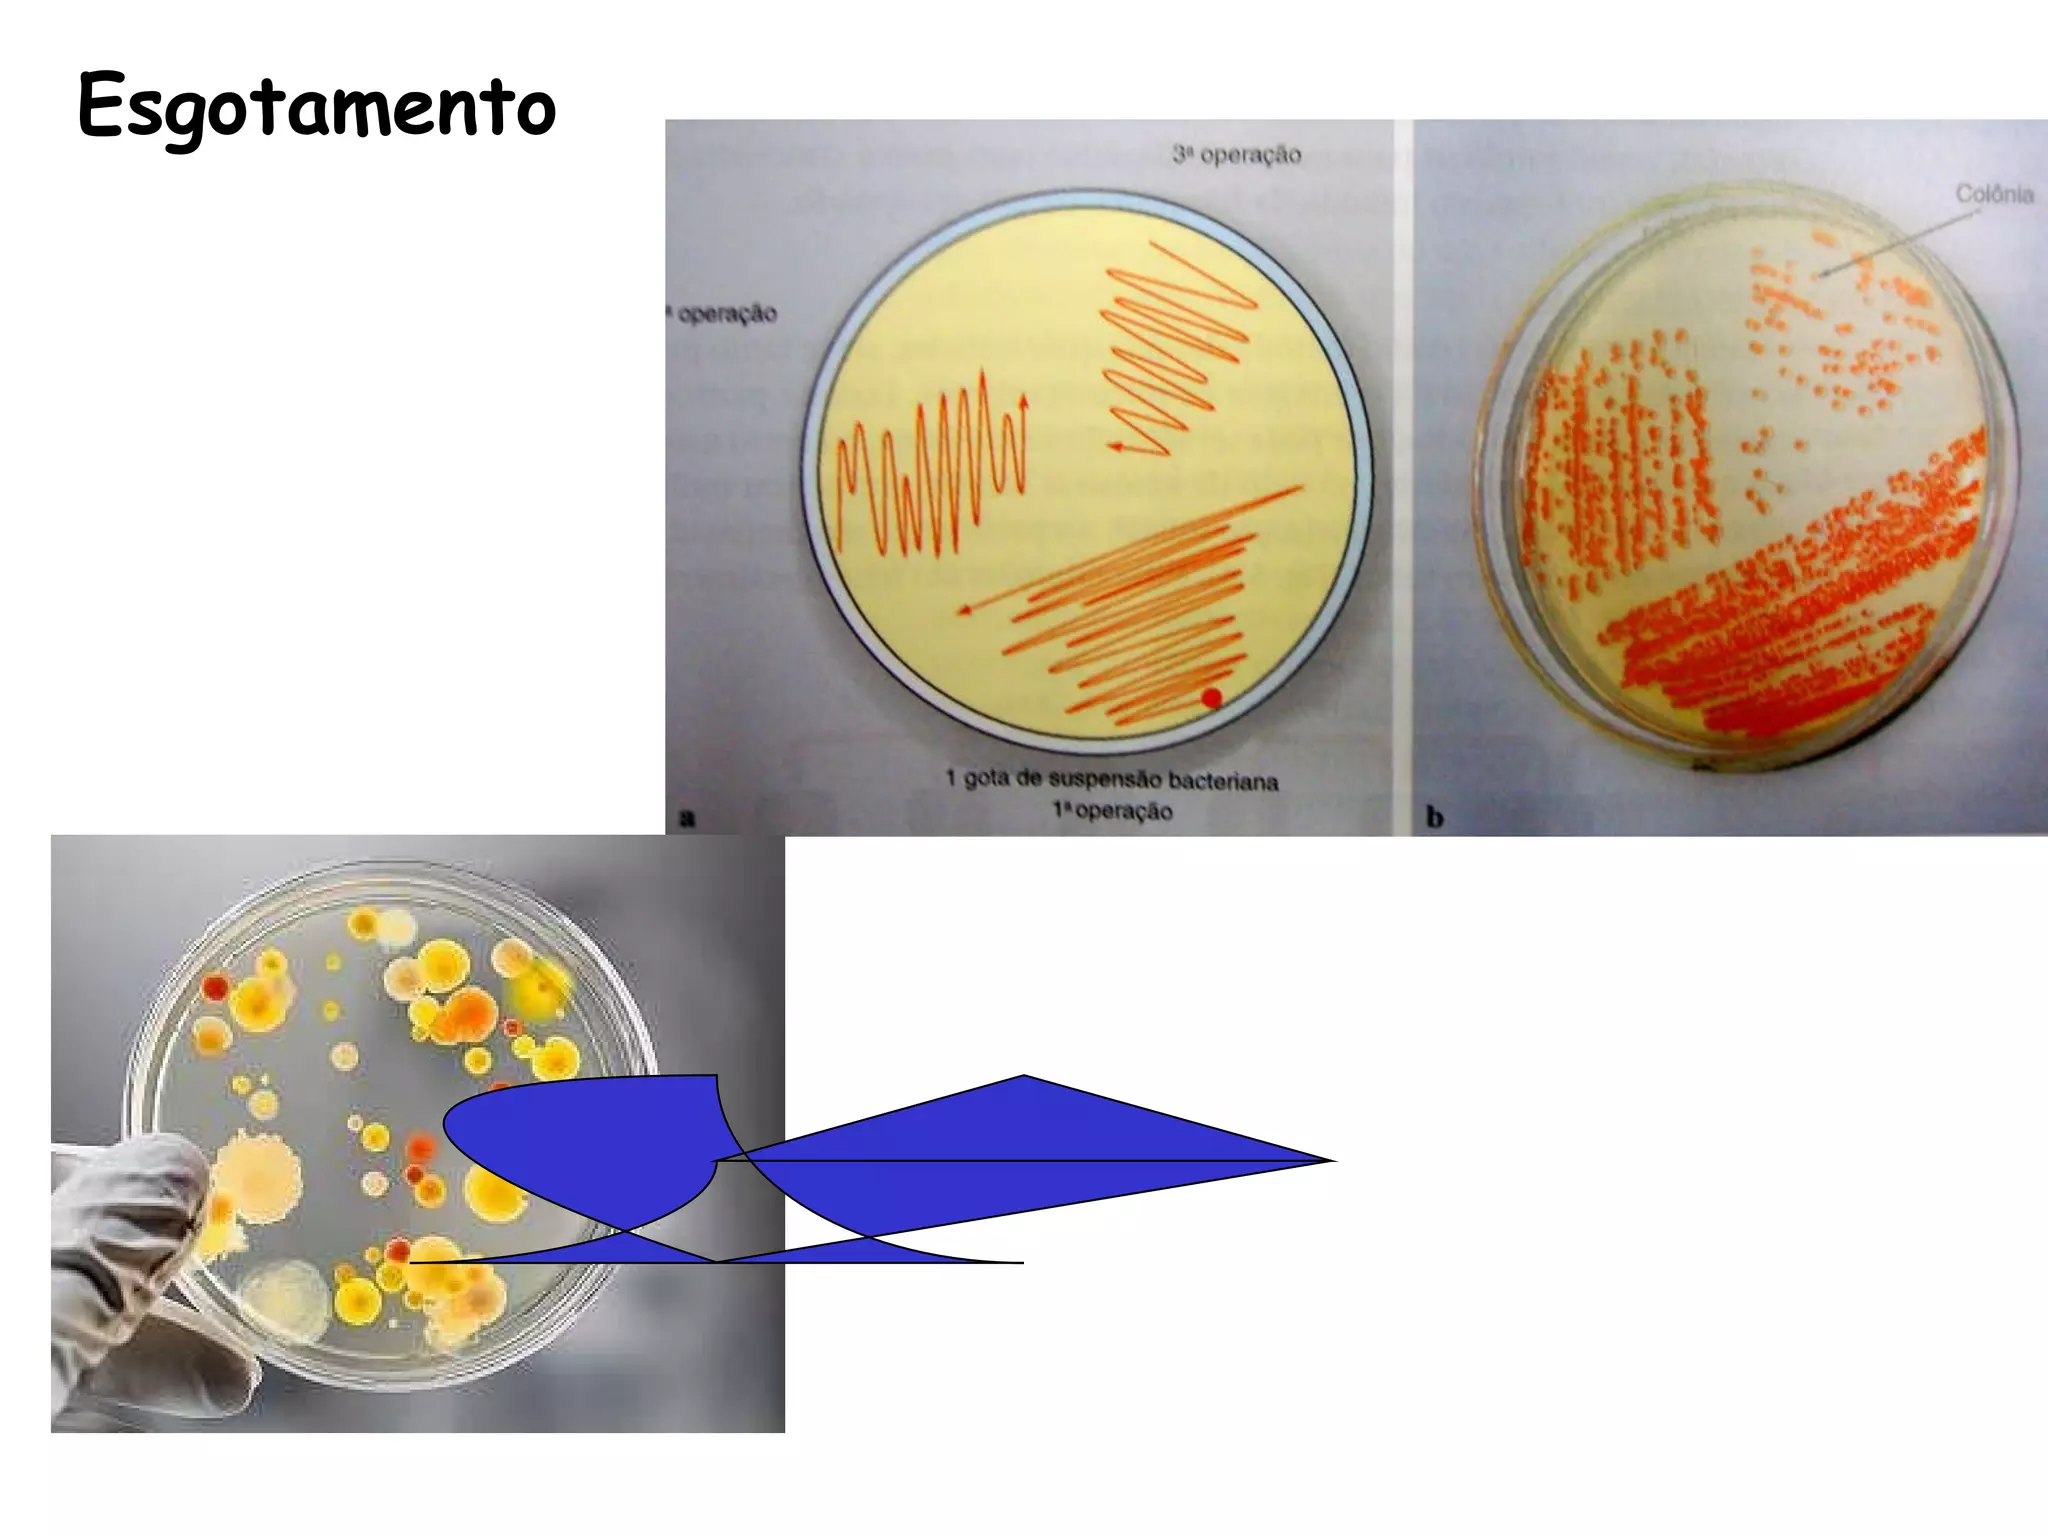
Esgotamento
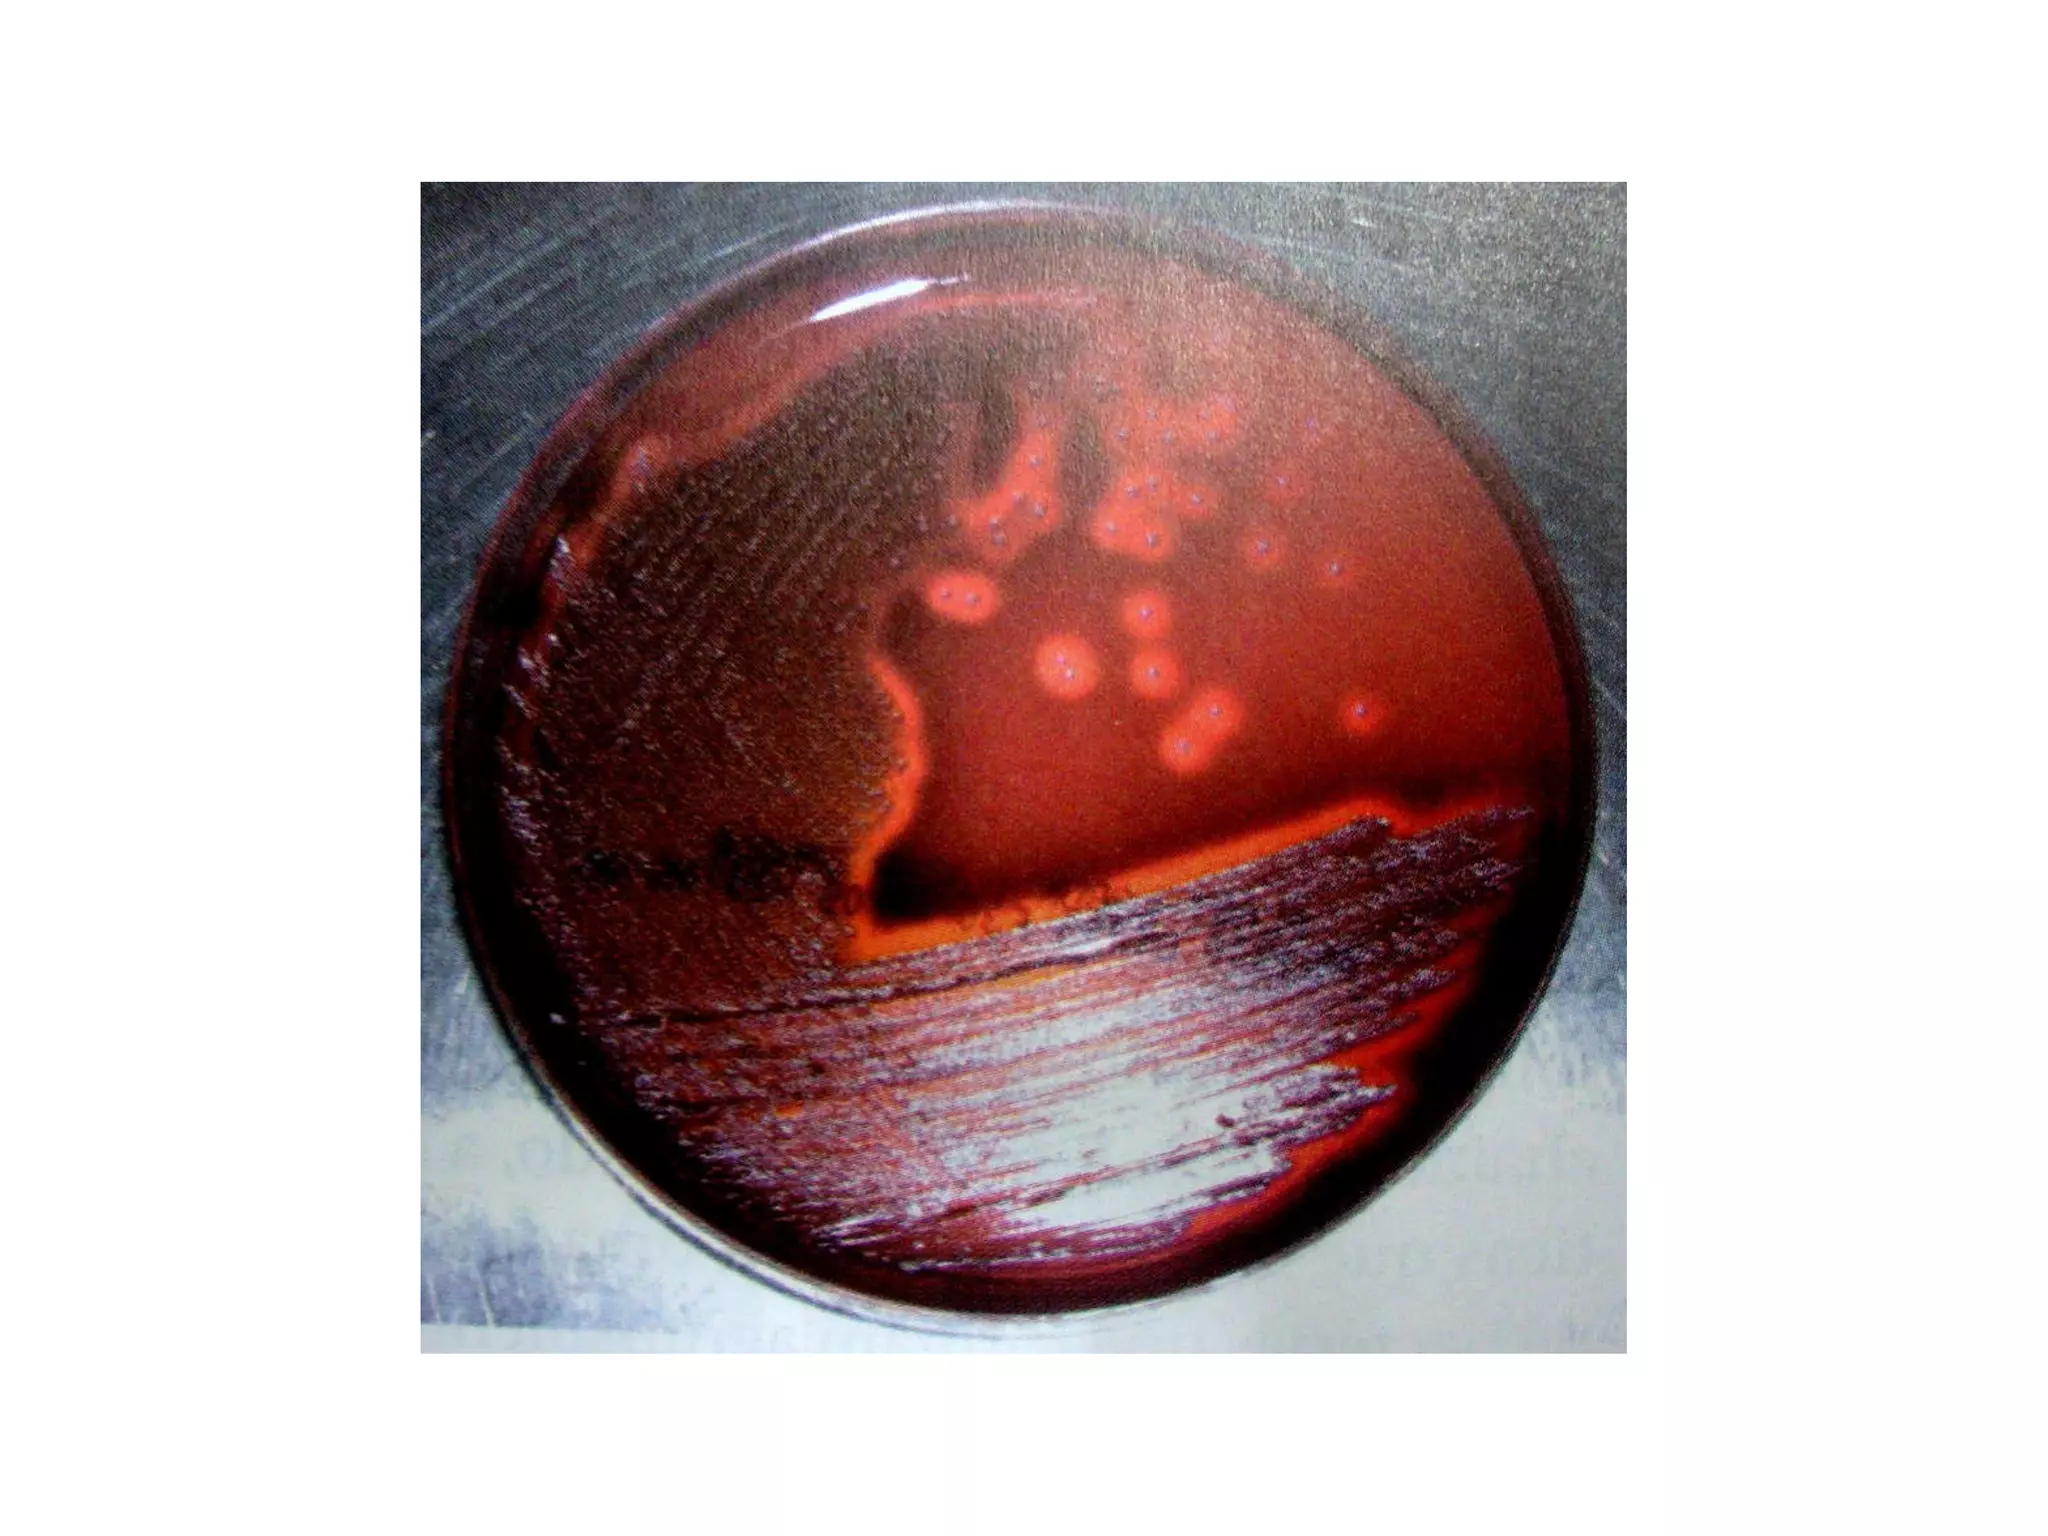

O documento descreve os procedimentos de segurança e técnicas básicas utilizadas em laboratório de microbiologia, incluindo normas de segurança, cultura pura, esterilização, assepsia e métodos físicos e químicos para controle do crescimento microbiano.